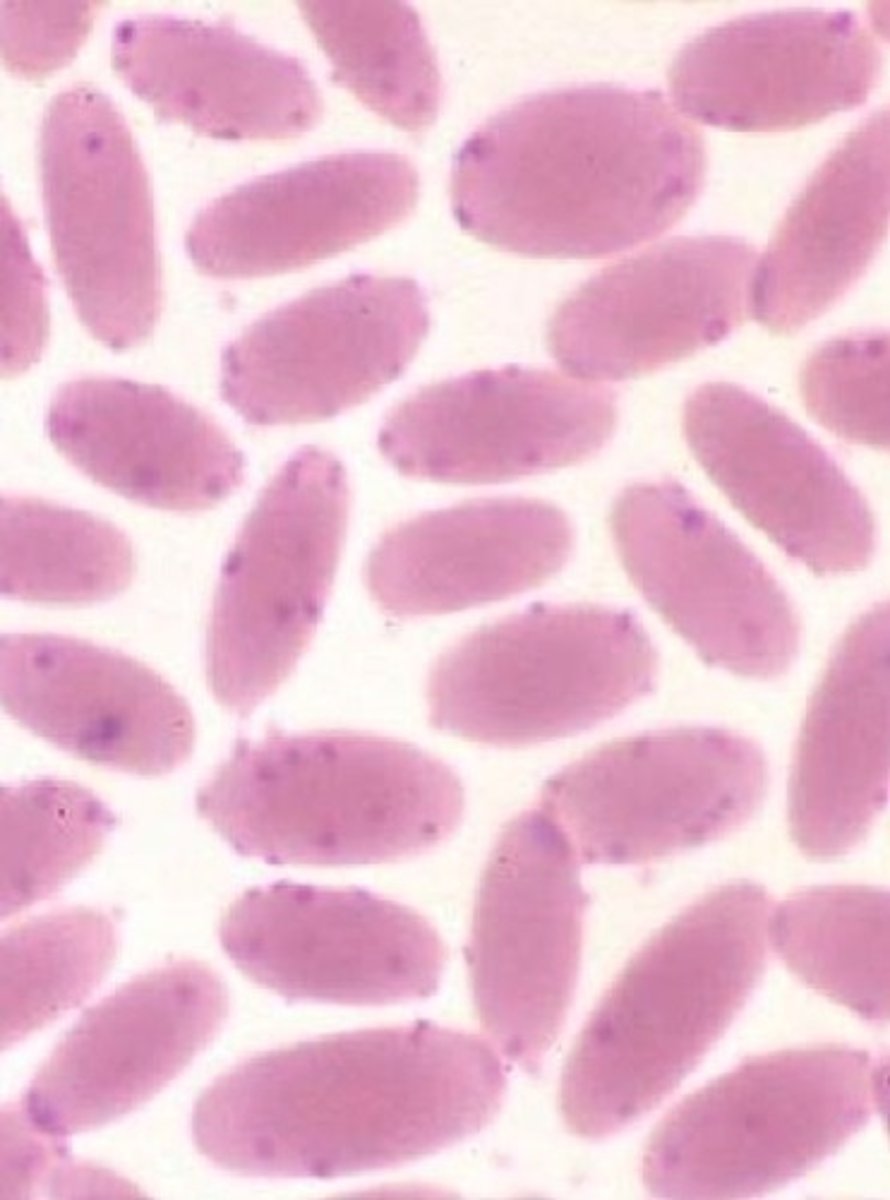
<p>A camelid presents with weight loss and anemia. This is seen. What do you think is going on, how do you diagnose, and what do you treat with since the animal is clinical?</p>

27 Camelid Lecture 2: Gastrointestinal
1/47
There's no tags or description
Looks like no tags are added yet.
Name | Mastery | Learn | Test | Matching | Spaced | Call with Kai |
|---|
No analytics yet
Send a link to your students to track their progress
48 Terms
Poor nutrition
Poor absorption (parasites, Johnes, IBD)
Chronic disease (Infections, Neoplasia)
But also dental disease, GI ulceration, Mycoplasma haemolama, and BVDV
What are the most common causes of weight loss in camelids?
HOT: Haemonchus, Ostertagia (Teladorsagia), Trichostrongylus
What are the most common trichostrongyle type GI parasites in camelids?
Coccidia, Trichuris (whipworm), Nematodirus
Besides the trichostronyle type GI parasites, what other GI parasites can be found in camelids?
Eimeria macusaniensis
TREATMENT: Ponazuril
What is the name of the highly pathogenic GI parasite in camelids that can cause diarrhea, weight loss, hypoproteinemia, dehydration, and death? How do you treat?

c. trichuris (whipworm) because it causes colitis & diarrhea
Which is considered to be VERY significant in camels:
a. coccidia
b. nematodirus
c. trichuris (whipworm)
Eimeria macusaniensis = must do fecal float
Fecal egg count does not show WHICH parasite? Meaning you have to do what to diagnose?
a. vaccine (for haemonchus)
b. bioworm
d. antihelminthics
e. copper oxide
Select which of the following you can use for parasite control in camelids:
a. vaccine
b. bioworm
c. zinc oxide
d. antihelminthics
e. copper oxide
f. penicillamine
Protein energy malnutrition
WHO ELSE: late pregnant females, lactating females, young/growing animals
A camelid with poor quality forage presents with weight loss and hypothermia with normal appetite. The animal is young and growing and it is early January. What do you think is happening? What other animals in the herd do you think will also be affected if they are on the same feed?
Persistently infected
What kind of camelids infected with BVDV tend to have a more grave prognosis, presenting with poor weight gain, diarrhea, intermittent illness, and pneumonia?
Mycoplasma haemolamae
Dx: blood smear & PCR (gold standard)
TREATMENT = oxytetracycline (NOT ORAL)
A camelid presents with weight loss and anemia. This is seen. What do you think is going on, how do you diagnose, and what do you treat with since the animal is clinical?
Lymphoma
What is the most common cancer seen in new world camelids?
PCR
What is the gold standard diagnosis for Mycoplasma hemolamae?
Stress
high grain diet
NSAIDs
What predisposes camelids to develop gastric ulceration?
Omeprazole OR pantoprazole
NOTE: gastric ulcers are a common necropsy finding
If a camelid develops gastric ulceration, what can you use to treat it?
Oral
What route of medication is basically not used in camelids because it it lowly bioavailavble?
Lymphoma
Remember ANY age/gender
Llamas with enlarged lymph nodes and anorexia with weight loss puts what at the top of your differentials list?
C3
What is the "true stomach" compartment in camelids?
Low albumin and anemia
What RBC and albumin changes would tip you off to gastric ulceration in camelids?
1-2 cm dorsal and 3-5cm caudal to costo-chondral junction of last rib (pocket of fluid)
different spot than other species
What is the collection site for abdominocentesis like in camelids?
Paratuberculosis (johne's disease)
IDB would be another good differential
A new world camelid presents with weight loss, diarrhea, and dependent edema with low protein. Thoughts?
By feeding cow colostrum to crias
How can camelids GET paratuberculosis (Johne's disease)?
Cows
Camelids have shorter incubation periods (<2 yrs) and NOT highly contagious in camelids
Which has a LONGER incubation for johne's disease and ultimately gets this disease more commonly, cows or camelids
Steroids
How can you treat eosinophilic enteritis (IBD) in camelids?
IBD = eosinophilic enteritis
Chronic diarrhea, weight loss, and low protein + tricavitary effusion tips you off to what in camelids?
Hepatic lipidosis seen more commonly in pregnant or lactating females because of higher energy demands
What is a common liver problem among camelids that affects all but more common in who?
Ongoing damage to the liver
SDH has a short half life. So if you see this, what does it mean?
AST and SDH (hepatocellular damage)
GGT (cholestasis)
Bile acids (hepatic function)
Name the enzymes that are increased with liver disease in camelids?
Percutaneous liver biopsy
How do you diagnose suspected hepatic lipidosis?
1. restore appetite (highly palatable food)
2. decrease stress
3. transfaunation
4. IV fluids
5. Insulin
6. Medications (b vitamins & selenium)
7. Supportive care
How do you treat hepatic lipidosis in camelids?
Fasciola hepatica, Fascioloides magna
Name the most common liver flukes in camelids
Snails, slugs
What is the intermediate host for liver flukes?
F. magna
Which is more common in the U.S.? Fasciola hepatica OR Fascioloides magna
ELISA
Eggs are not always found in fecal floats for liver flukes. So how can you diagnose them?
Clorsulon and Albendazole
What are the treatments for liver flukes in camelids?
Mandibular cheek teeth because they have 2 prominent roots
What teeth most commonly get tooth root abscesses in camelids, why?
Tooth root abscess --> CT to diagnose
A camelid presents with swelling around the mandibular cheek teeth, draining tracts, and weight loss. What are your next steps for your top differential?
Florfenicol
What antibiotic can be used to treat tooth root abscess in camelids?
Physical/oral exam
Fecal float and BW
Adjust nutrition
Supportive care
Rule out neoplasia if no response
Rule out M. haemolamae with PCR
Give steroids as a final effort to treat IBD
What is the clinical approach for a camelid presenting with weight loss?
C1
Which chamber of the stomach will be atonic with colic in camelids?
Oro-gastric intubation + get them to lower the neck
How do you relieve choke in camelids?
Choke
common emergency in camelids
A camelid with gagging and regurgitation that presents sick after eating is likely affected by WHAT?
hairballs = aggregation of hair, fiber, and plant fiber
What does Trichobezoars mean in camelids?
Younger before weaning
What age of camelids commonly gets trichobezoars or hairballs?
Pylorus, duodenum, spiral colon
Which parts of the GI tract tend to get trichobezoars or hairballs in camelids?
Grinding teeth, uncomfortable, rolling/laying down, kicking, C1 atony
Colic tends to be more subtle in camelids in comparison to horses. Name some symptoms
b. enteroliths
d. bezoars
e. hernia
Select which of the problem are considered surgical in camelids:
a. C1 acidosis
b. enteroliths
c. peritonitis
d. bezoars
e. hernia
f. enteritis
a. uterine torsion
d. colon impaction
f. gastric impaction
Select which of the problem are considered surgical AND medical in camelids:
a. uterine torsion
b. enteroliths
c. peritonitis
d. colon impaction
e. hernia
f. gastric impaction
c. cystitis
e. C1/C3 ulcers and acidosis
f. parasitosis
Select which of the problem are considered medical in camelids:
a. volvulus
b. urolithiasis
c. cystitis
d. bezoars
e. C1/C3 ulcers and acidosis
f. parasitosis